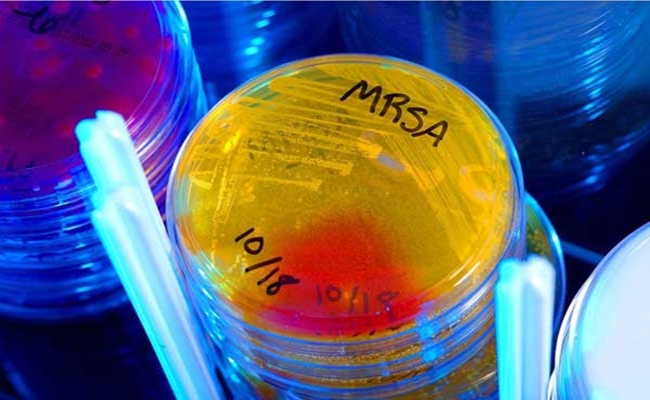

علماء يكسرون مقاومة البكتيريا العصية بالضوء الأزرق
طوّر العلماء الأميركيون “جهاز جيب” يستخدم أشعة زرقاء لكسر مقاومة البكتيريا العصية، التي تتوقع منظمة الصحة العالمية أن تقتل 10 ملايين إنسان على المستوى العالمي حتى سنة 2050.
ويقدر العلماء نسبة البكتيريا العصية على المضادات الحيوية (Multiresistentbacteria MRSA) بنحو 10% من مجموع البكتيريا المرضية المعروفة. ويمكن بالطبع أن يزداد عددها، وأن تزداد شراستها في المستقبل.
تفوقت البكتيريا في تطوير مقاومتها للمضادات الحيوية تفوقت على العلماء، الذين يطوّرون هذه المضادات الحيوية، ويمكن أن تؤدي هذه الحال مستقبلًَا إلى زيادة عدد ضحايا البكتيريا المقاومة على عدد ضحايا السرطان، بحسب دراسة ألمانية حديثة طرحت على قمة السبع الكبار في أيلمناو في ولاية بافاريا.
كتب العلماء الأميركيون في مجلة “أدفانسد ساينسيس” أنهم استخدموا الضوء الأزرق بنجاح في كسر شوكة البكتيريا المقاومة للمضادات الحيوية. وأفادوا أن اللون الأزرق غيّر لون بقعة ملونة معيّنة في جدران هذه البكتيريا، وأن هذا التغيّر في اللون مكّن المضادات الحيوية لاحقًا من قتلها.
وبحسب ما اوردت صحيفة “إيلاف”، أضعفت أشعة اللون الأزرق، من طول موجات معيّن، أضعفت مقاومة البكتيريا العصية، وجعلتها حساسة للمضادات الحيوية السائدة في الصيدليات. بل إن مادة مطهرة اعتيادية، مثل بيروكسيد الهيدروجين، تمكنت من قهر هذه البكتيريا بعد تعريضها للضوء الأزرق.
كان المركز الأوروبي للوقاية والرقابة على الأمراض (ECDC) نشر دراسة في سنة 2015 رصد فيها إصابة 762 ألف أوروبي ببكتيريا عصية على المضادات الحيوية. وسجل المركز موت 33100 شخص منهم بسبب مضاعفاتها.
تعتبر بكتيريا ستافيلوكوكوس أوريوس من أكثر البكتيريا المستعصية على المضادات الحيوية انتشارًا في العالم، وخصوصًا الأنواع المحسوبة منها على (MRSA). وهي بكتيريا تنتشر في الكثير من المستشفيات التي تعاني من مشاكل في التعقيم والتطهير. وتستمد هذه البكتيريا قوتها في الجسم من عجز جهاز المناعة الذاتي عن مقاومتها.
كتب بو تينغ دونغ، من جامعة بوسطن، أن فريق عمله توصل إلى طريقة تستخدم الضوء الأزرق في كسر مقاومة الستافيلوكوكوس أوريوس. واستخدم العلماء الضوء الأزرق لتغيير لون بقعة ملونة في جدران هذه الخلايا، في عملية تعرف علميًا باسم “القصر الضوئي”.
تستخدم معظم أنواع البكتيريا المقاومة للمضادات الحيوية بعض الصبغات التي تختلف مهماتها ووظائفها من بنوع بكتيري إلى آخر، ولكنها تضطلع في جدران الخلايا بمهمة الدفاع عن البكتيريا ضد الأعداء الخارجيين.
مختبريًا، استخدم دونغ وزملاؤه صبغة كاروتينيويد ستافيلوزانتين التي تتواجد عادة في جدران خلايا بكتيريا ستافيلوكوكوس أوريوس المقاومة للمضادات الحيوية. ثم عرض العلماء هذه الصبغة إلى اللون الأزرق في محاولة لقصرها ضوئيًا.
أضاف محمود سليم، من جامعة بردو في ويست لافاييت، والذي ساهم في الدراسة، إن القصر الضوئي لا يختلف عن عملية قصر ألوان الملابس في الغسالة، فضلًا عن أن العلماء استخدموا الضوء الأزرق بدلًا من المواد الكيميائية القاصرة التي تستخدم في الغسيل.
اكتشف دونغ في التجارب المختبرية أن أفضل عملية قصر ضوئي لصبغة كاروتينيويد ستافيلوزانتين تجري في موجات ضوئية من طول 460 نانوميتر، أي في الضوء الأزرق.
ثبت بعد قصر هذه الصبغة في جدران البكتيريا أن هذه الجدران غيّرت نفاذيتها، وصارت تسرب العديد من المواد الخارجية إلى داخل الخلية. وهذا جعلها بالتالي أكثر عرضة لهجمات المضادات الحيوية.
وكتب فريق العلماء أن عملية التحلل الضوئي لصبغة كاروتينيويد ستافيلوزانتين بتأثير الضوء الأزرق جعل بكتيريا ستافيلوكوكوس أوريوس ضعيفة أمام أبسط المضادات الحيوية، بما فيها بعض أنواع المواد المطهرة. وعبّر الباحثون عن ثقتهم بأنهم عثروا على طريقة جديدة لكسر شوكة البكتيريا العصية من نوع MRSA.
يقول دونغ إن معالجة الجروح الخارجية الملوثة بالبكتيريا العصية صعب جدًا، لكن المضادات الحيوية تمكنت من معالجة هذه الجروح بعد تسليط الضوء الأزرق عليها. وأجرى فريق العمل تجاربه على فئران تعمدوا إصابتها بجروح MRSA، فتمكن الضوء الأزرق من قهر البكتيريا وتمكين اندمال الجروح.
ينتظر دونغ وزملاؤه أن تنتهي تجارب أخرى، باستخدام الضوء الأزرق، بنجاح، كي يمكن اعتماد الطريقة في معالجة الإصابات بالبكتيريا الشديدة المقاومة للمضادات الحيوية.
ويؤكد العلماء أنهم طوّروا سلفًا جهازًا صغيرًا للجيب يطلق اللون الأزرق بطول موجات معيّن، ويمكن تسليط ضوئه على الجروح المستعصية على الشفاء.
ذكر الباحث محمود سليم أن الجهاز صغير وسهل الاستعمال، وأنهم يأملون في المستقبل أن يضعه أي شخص في جيب سترته. ومن يدري ربما ينتج الجهاز بشكل تطبيق يضاف إلى الهاتف الجوال يومًا ما.
جدير بالذكر أن الأطفال تحت سن 12 شهرًا، والبالغين من هم في سن تزيد على 65 سنة، أكثر عرضة لهجمات البكتيريا العصية من غيرهم. وتعجز المضادات الحيوية القوية، والمضادات الحيوية الاحتياطية (كآخر سلاح)، عن قتل هذه البكتيريا في 39% من الحالات. وتصبح هذه الإصابات عصية على العلاج أو منيعة تمامًا عليه في آلاف الحالات.